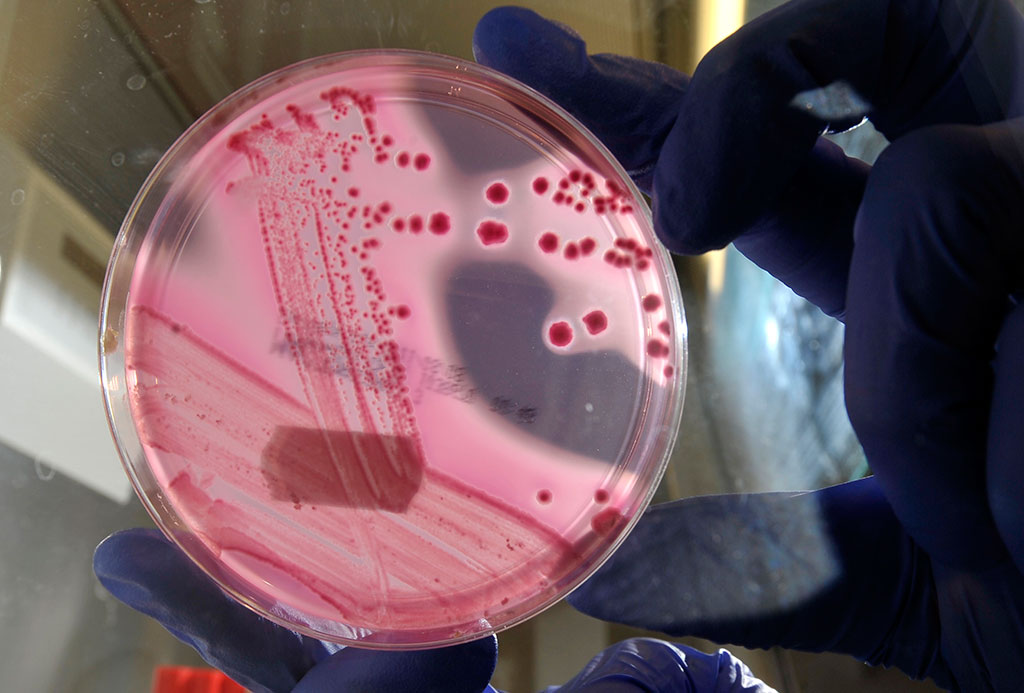
img_2987

Американские диетологи утверждают, что популярный бутерброд из категории “фаст фуда” хот-дог вызывает рак.
Об этом сообщает Сегодня.
Как правило, при производстве хот-догов используют свинину, говядину и куриное мясо. Но кроме этого, весь процесс также включает добавление других ингредиентов. В фарщ может идти кожа, жир, ножки и когти, а также многочисленные добавки, такие как соль, кукурузный сироп, глутамат натрия, предназначенных для усиления вкуса., говорят исследователи.
Самым опасным является процесс создания мононатриевых глутаматных и карминовых ароматов, которые создаются из скорлупы мелких жуков, вареных в аммиаке и карбонате натрия.
Более того, исследование, проведенное в Гавайском университете, показало, что обработанное мясо повышает шансы на развитие рака поджелудочной железы на 67%.
В это мясо входят добавки, такие как нитриты и нитраты, которые являются чрезвычайно опасными ингредиентами, повышающие риск развития рака поджелудочной железы, рака кишечника, рака мочевого пузыря и рака желудка.
По данным Американского института исследований рака, только один хот-дог может повысить риск колоректального рака на 21%.